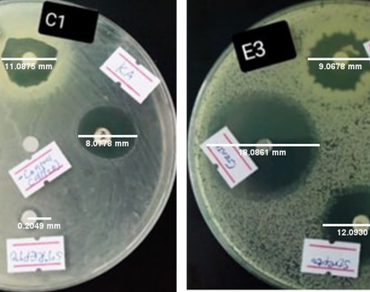
Antibacterial activity, Crude ethanol extract, Disc diffusion, Medicinal plant, Phytochemical screening, n                     Vernonia auriculiferan

Phytochemical analysis and antibacterial activity of ethanol leaf extract of Vernonia auriculifera Hiern (Asteraceae)
*Article not assigned to an issue yet
Research Articles | Published: 26 March, 2026
First Page: 0
Last Page: 0
Views: 95
Keywords: Antibacterial activity, Crude ethanol extract, Disc diffusion, Medicinal plant, Phytochemical screening, n Vernonia auriculiferan
Abstract
Medicinal plants of the genus, Vernonia are flowering shrubs in the family Asteraceae, comprise over 500 species distributed across tropical and subtropical regions, particularly in Africa and South America. Many species of this genus are traditionally used to treat various human illnesses due to their diverse bioactive phytochemicals. medicinal properties in treating various health conditions. Vernonia auriculifera, an indigenous Ethiopian medicinal plant locally known as Gujo or Regi (Amharic) and Reji (Afan Oromo), has been conventionally used for wound treatment and other medical uses. This study examined the phytochemical composition and antibacterial activity of the crude ethanol leaf extract of V. auriculifera. Qualitative phytochemical screening the presence of flavonoids, tannins, saponins, terpenoids, and phlobatannins, while alkaloids and steroids were not noticed. Antibacterial activity was evaluated against four clinical human pathogenic bacterial strains (Staphylococcus aureus, Streptococcus agalactiae, Escherichia coli and Shigella boydii) using the disc diffusion method and minimum inhibitory concentration (MIC) assay. The extract exhibited concentration-dependent antibacterial activity with inhibition zones ranging from 7.83 ± 0.12 mm to 16.17 ± 0.07 mm. Gram positive bacteria showed greater susceptibility compared to Gram negative bacteria. The MIC values were 50 mg/mL for Gram-positive strains and 100 mg/mL for Gram-negative strains. Though the antibacterial strength of the extract required relatively high concentrations, the findings indicate the presence of bioactive compounds that may contribute to antimicrobial activity. These conclusions support the traditional use of V. auriculifera and highlight its potential as a source of plant based antimicrobial compounds. Further studies involving quantitative phytochemical screening and bioassay guided fractionation are recommended to identify the active compounds responsible for the observed antibacterial activity.
References
Albejo B, Endale M, Kibret B, Anza M (2015) Phytochemical investigation and antimicrobial activity of leaves extract of Vernonia auriculifera Hiern. J Pharm Pharmacognosy Res 3(6):141–147. https://doi.org/10.56499/jppres15.088_3.5.141
Annisa R, Dewi TJD, Mutiah R, Nurjanah S (2021) Journal of Pharmacy and Chemistry. J Trop Pharm Chem 5(4):396–405. https://jtpc.farmasi.unmul.ac.id
Badalova K (2023) mesmap-9 abstract proceeding book 2023 The 9 th International Mediterranean Symposium on Medicinal and Aromatic Plants 03–05 May 2023 / Ankara - TURKIYE (Issue May)
Bahiru M, Tafesse G, Chauhan NM, Assefa E (2020) Antimicrobial activity of crude extract from Millettia ferruginea leaves and barks against selected bacterial pathogens and Candida albicans. J Microbiol Antimicrobials 12(2):81–87 https://doi.org/10.5897/JMA2019.0409
Batool K, Sultana S, Akhtar N, Muhammad H, Naheed A (2018) Medicinal plants combating against human pathogens: A review. Int J Biotechnol Food Sci 6(3):42–51
Bitew H, Gebregergs H, Tuem KB, Yeshak MY (2019) Ethiopian medicinal plants traditionally used for wound treatment: A systematic review. Ethiop J Health Dev 33(2):102–127
Bontzolis CD, Dimitrellou D, Plioni I, Kandylis P, Soupioni M, Koutinas AA, Kanellaki M (2024) Effect of solvents on aniseed aerial plant extraction using soxhlet and ultrasound methods, regarding antimicrobial activity and total phenolic content. Food Chem Adv 4(January):100609. ttps://doi.org/10.1016/j.focha.2024.100609
CLSI M07 (2018) Clinical and Laboratory Standards Institute Methods for Dilution Antimicrobial Susceptibility Tests for Bacteria That Grow Aerobically. Clinical and Laboratory Standards Institute (CLSI), 91
Erba O, Chimdessa Egigu M, Erba Urgessa O, Egigu MC, Kebede A (2023) Plant secondary metabolite screening for in vitro antimicrobial activities of the extracts of guava (Psidium guajava L.) against enteric bacterial pathogens. April. https://www.researchgate.net/publication/370231531
Gelata A, Jemal M, Gershe S, Abdissa N (2024) Chemical Constituents and Evaluation of Bioactivity of Vernonia hymenolepis A. Rich Root Extracts 13(2):595–600. https://doi.org/10.14421/biomedich.2024.132.595-600
Gordon TR (2017) Fusarium oxysporum and the Fusarium Wilt Syndrome. Annu Rev Phytopathol 55:23–39. https://doi.org/10.1146/annurev-phyto-080615-095919
Karfi IA, Zango UU, Olatinwo T, M Suleiman (2021) Phytochemical screening and antibacterial activity of Vernonia amygdalina (bitter leaf) on some selected bacterial isolates. Int J Biology Pharm Res Archive 1(1):006–013. https://doi.org/10.53771/ijbpra.2021.1.1.0013
Intan PR, Noviantari A, Alegantina S (2023) Response to Article Evaluation of the Antioxidant and Wound Healing Properties of 80% Methanol Extract and Solvent Fractions of the Leaves of Vernonia auriculifera Hiern. (Asteraceae) [Letter]. Clin Cosmet Invest Dermatology 16(January):1107–1108. https://doi.org/10.2147/CCID.S417345
Keneni YG, Bahiru LA, Marchetti JM (2021) Effects of Different Extraction Solvents on Oil Extracted from Jatropha Seeds and the Potential of Seed Residues as a Heat Provider. Bioenergy Res 14(4):1207–1222. https://doi.org/10.1007/s12155-020-10217-5
Kenmeni JF, Sifi I, Bisso BN, Kayoka-Kabongo PN, Tsopmene UJ, Dzoyem JP (2024) Exploring Medicinal Plants for Antimicrobial Activity and Synergistic Effects With Doxycycline Against Bacterial Species. TheScientificWorldJournal 2024:6238852. https://doi.org/10.1155/2024/6238852
Kumari K, Adhikari P, Pandey A, Samant SS, Lal M, Pande V (2024) Influence of Solvent Polarity on Phytochemicals, Antioxidants, and Antimicrobial Properties of Delphinium denudatum: A Medicinal Herb from Sainj Valley, Himachal Pradesh, India. Bioactivities 2(1):30–40. https://doi.org/10.47352/bioactivities.2963-654x.214
Majhi R, Maharjan R, Shrestha M, Mali A, Basnet A, Baral M, Duwal R, Manandhar R, Rajbhandari P (2023) Effect of altitude and solvent on Psidium guajava Linn. leaves extracts: phytochemical analysis, antioxidant, cytotoxicity and antimicrobial activity against food spoilage microbes. BMC Chem 17(1):1–16. https://doi.org/10.1186/s13065-023-00948-9
Manilal A, Sabu KR, Tsefaye A, Teshome T, Aklilu A, Seid M, Kayta G, Ayele AA, Idhayadhulla A (2023) Antibacterial Activity Against Multidrug-Resistant Clinical Isolates of Nine Plants from Chencha, Southern Ethiopia. Infect Drug Resist 16:2519–2536. https://doi.org/10.2147/IDR.S402244
Molla Y, Nedi T, Tadesse G, Alemayehu H, Shibeshi W (2016) Evaluation of the in vitro antibacterial activity of the solvent fractions of the leaves of Rhamnus prinoides L’Herit (Rhamnaceae) against pathogenic bacteria. BMC Complement Altern Med 16(1):1–9. https://doi.org/10.1186/s12906-016-1279-6
Muluye AB, Ayicheh MW (2020) Medicinal plants utilized for hepatic disorders in Ethiopian traditional medical practices: a review. Clin Phytoscience 6(1). https://doi.org/10.1186/s40816-020-00195-8
Oncho DA, Ejigu MC, Urgessa OE (2021) Phytochemical constituent and antimicrobial properties of guava extracts of east Hararghe of Oromia, Ethiopia. Clin Phytoscience 7(1). https://doi.org/10.1186/s40816-021-00268-2
Pérez L, Jessica G, Rodríguez M, Quirós Y, Michel M, Mora L (2023) Antifungal activity of Mosiera bullata (Britton & P. Wilson) extract against phytopathogenic fungi. Vegetos 36(4):1295–1304. https://doi.org/10.1007/s42535-022-00540-x
Sharifi-Rad J, Salehi B, Stojanović-Radić ZZ, Fokou PVT, Sharifi-Rad M, Mahady GB, Sharifi-Rad M, Masjedi MR, Lawal TO, Ayatollahi SA, Masjedi J, Sharifi-Rad R, Setzer WN, Sharifi-Rad M, Kobarfard F, Rahman A ur, Choudhary MI, Ata A, Iriti M (2020) Medicinal plants used in the treatment of tuberculosis - Ethnobotanical and ethnopharmacological approaches. Biotechnology Advances, 44(December 2016), 107629. https://doi.org/10.1016/j.biotechadv.2020.107629
Shetty SB, Mahin-Syed-Ismail P, Varghese S, Thomas-George B, Kandathil-Thajuraj P, Baby D, Haleem S, Sreedhar S, Devang-Divakar D (2016) Antimicrobial effects of Citrus sinensis peel extracts against dental caries bacteria: An in vitro study. J Clin Experimental Dentistry 8(1):e71–e77. https://doi.org/10.4317/jced.52493
Sinze Metiave AA, Tedonkeu AT, Tamokou JDD, Nanfack ARD, Matsuete-Takongmo G, Wetadieu K, Tsopmo D, A., Tene M (2023) Antibacterial stigmastane-type steroids and other constituents from the leaves of Vernonia glabra (Steetz) Vatke (Asteraceae). Nat Prod Res 0(0):1–15. https://doi.org/10.1080/14786419.2023.2278756
Sudira IW, Merdana IM, Qurani SN (2019) Preliminary Phitochemical Analysis Of Guava Leaves (Psidium guajava L.) Extract As Antidiarrheal In Calves. Adv Trop Biodivers Environ Sci 3(2):21. https://doi.org/10.24843/atbes.2019.v03.i02.p01
Tesfaye S, Belete A, Engidawork E, Gedif T, Asres K (2020) Ethnobotanical Study of Medicinal Plants Used by Traditional Healers to Treat Cancer-Like Symptoms in Eleven Districts, Ethiopia. Evidence-Based Complement Altern Med 2020. https://doi.org/10.1155/2020/7683450
Wado TE, Suleman S, Mohammed T (2022) Antimicrobial Evaluation of Sequentially extracted Leaf of Vernonia auriculifera Hiern (Rejicho). BMC Complement Med Ther 22(1):1–10. https://doi.org/10.1186/s12906-022-03690-2
Author Information
Department of Biotechnology, College of Natural and Computational Sciences, Wachemo University, Hossana, Ethiopia